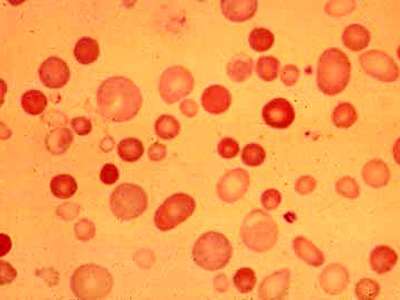
анизоцитоз

Содержание
Когда делают клинический анализ, то оценивают не только количество клеток крови, но и их качество. При диагностировании болезней общие характеристики, включающие в себя размер, форму и оттенок, имеют очень важное значение. В большинстве случаев данные характеристики считаются единственным патогномоничным симптомом какой-либо болезни. Поэтому опытные специалисты-гематологи просят своих сотрудников указывать в клиническом анализе RDW с правильным распределением эритроцитов по величине.
Коэффициент RDW

Коэффициент анизотропии (RDW) указывает на неоднородность кровяных частиц. Данный индекс называют мерой несхожести эритроцитов, которая сигнализирует об отклонении в объеме кровяных частиц. Данный коэффициент является вспомогательным критерием при диагностике анемии. Изменение объема кровяных частиц уменьшается с возрастом. Также причиной может быть рак или наличие опухоли. Формирование разных по объему кровяных частиц называют анизоцитозом.
Врачи отмечают, что коэффициент анизотропии эритроцитов является важным показателем, который может свидетельствовать о состоянии здоровья пациента. Этот параметр отражает степень изменения формы красных кровяных клеток, что может быть связано с различными заболеваниями, такими как анемия, инфекции или даже онкологические процессы. Специалисты подчеркивают, что высокий коэффициент анизотропии может указывать на наличие воспалительных процессов в организме, а также на нарушения в кроветворении. Важно, чтобы врачи учитывали этот показатель в комплексе с другими анализами и клиническими данными для более точной диагностики. Регулярный мониторинг анизотропии эритроцитов может помочь в раннем выявлении заболеваний и своевременном начале лечения, что в конечном итоге улучшает прогноз для пациентов.

RDW SD

Расчетная величина указывается в фемтолитрах (фл). Нормой является показатель 42±5 фл.
RDW CV
Для определения гетерогенности эритроцитов применяют второй метод исследования – RDW CV. Он является относительной шириной распределения кровяных частиц по объему. Опытные специалисты называют данный коэффициент индексом вариации. На данный показатель влияет MCV. При его колебаниях может наблюдаться увеличение коэффициента вариации. Это значит, что необходимые показатели нужно рассчитывать по специальной формуле:
RDW-CV= SD/ MCV×100
В данной формуле SD является стандартным среднеквадратическим отходом объема кровяных частиц от их среднего показателя. Часть формулы RDW-CV означает разницу объема красных частиц от среднего показателя SD. Данный индекс указывается в процентах. Норма такого показателя равна 11,5-14,5%. При данных значениях существует гомогенная популяция клеток. Она включает в себя нормоциты, микроциты и макроциты.
Коэффициент анизотропии эритроцитов — это важный показатель, который привлекает внимание как специалистов, так и пациентов. Многие люди интересуются, как этот параметр влияет на здоровье. В медицинских кругах обсуждается, что анизотропия может свидетельствовать о различных заболеваниях, включая анемию и сердечно-сосудистые патологии. Некоторые пациенты отмечают, что понимание этого показателя помогает им лучше осознать состояние своего организма и важность регулярных анализов. В то же время, существует мнение, что не все врачи достаточно подробно объясняют значение коэффициента, что порождает недопонимание. В социальных сетях можно встретить обсуждения, где люди делятся своим опытом и задают вопросы о том, как анизотропия влияет на общее состояние здоровья. Это подчеркивает необходимость повышения информированности и доступности информации о таких медицинских показателях.

Анализ определения
Для того чтобы узнать, повышен или понижен ли показатель RDW, рекомендуется сдать венозную кровь.

Данный анализ сильных болевых ощущений не вызывает. Но на месте прокола кожного покрова образовывается слабая гематома. Она может появиться у тех людей, у которых повышен уровень сахара или гемоглобин. В момент реабилитации слабая гематома осложнений не вызывает.
Для того, чтобы убрать любую боль, во время сбора крови, рекомендовано потереть или надавить подушечку пальца. Такую процедуру проделывают маленьким детям во время забора крови из вены. Для установления точного диагноза все полученные результаты направляют специалисту. Врач назначает необходимое лечение. В том случае, если уровень эритроцитов понижен или повышен, это указывает на возникновение какой-либо болезни. Специалист находит причину возникновения повышенного или пониженного уровня, затем обращает внимание на реакции, произошедшие в виду данных результатов.
Видео о методике забора крови

Повышенные значения
Если уровень эритроцитов повышен более чем на 15%, это значит, что в крови человека есть неоднородные по объему клетки. К ним причисляют макроциты, нормоциты и шизоциты. Чем выше значение показателя, тем больше расхождение красных частиц в размерах и объеме.
Данный диагноз принято считать анизоцитозом.
- При наличии микроцитарной или железодефицитной анемии;
- Необратимых патогенных процессов;
- Эритмии, хронического лейкоза;
- Порока сердца;
- Трансфузии кровяного потока;
- Увеличении вязкости крови;
- Недостатка фолиевой кислоты;
- Миелодиспластического синдрома, а также болезней Аэрза, Пиквика;
- Врожденного или приобретенного алкоголизма;
- Употребления загрязненной или хлорированной воды;
- Онкологической патологии с наличием метастаз в костном мозге;
- Пневмонии, нарушения функции дыхательных путей, воспаления бронхов;
- Долгого пребывания в гористой местности, в которой недостаточно воздуха;
Признаками повышенного уровня до 8-12 единиц является наличие эритремии, а также острой формы лейкоза. В этом случае у людей начинается усиленная выработка кровяных частиц. Может наблюдаться легочная или сердечная недостаточность. Может начаться патология сосудов. В качестве признаков наблюдается вязкость крови, которая вызывает нарушение режима, диарею, обезвоживание организма.
Пониженные значения
Если уровень кровяных частиц понижен, то это значит, что организм человека обезвожен.
В большинстве случаев пониженные значения являются следствием потери крови или нехватке витаминов. Признаки пониженного показателя могут быть приобретенными или передаваться по наследству. В случае генетики человек обязан проходить диагностирование минимум один раз в полгода. На сегодняшний момент все причины изучены полностью. Но вылечить последствия заболевания окончательно не всегда предоставляется возможным.
Причины пониженного уровня кровяных частиц:
- Генетическая онкология;
- Наличие рака, опухолей;
- Лейкоз или возникновение миеломы;
- Развитие гемолиза, сильные повреждения кровяных частиц с выходом гемоглобина;
- Нехватка жизненно важных витаминов;
- Плохое питание;
- Нарушение сна, бессонница;
- Нехватка в организме человека железа;
- Сильная потеря крови;
- Патологический эритроцитарный распад;
К признакам можно отнести разные ступени. К первой относятся данные, равные 30-50%. В этом случае клетки имеют незначительное расхождение по объему и размерам. Ко второй ступени изменение диаметра эритроцитов на 50-70%.
К третьей, наиболее тяжелой ступени, причисляют сильное трансформирование клеток более чем на 70%.
Что предпринимать?
Рекомендовано пройти тщательную диагностику организма. Необходимо выявить причину неправильного уровня. Только после выявления причины или поставленного диагноза следует начинать лечение. Необходимо устранить факторы и причины появления разноразмерных кровяных частиц.
В случае, если диагноз поставлен не был, то изменение объема лейкоцитов указывает на неправильный образ жизни. В этом случае необходимо изменить распорядок дня, увеличить количество часов сна, придерживаться рекомендуемой диеты. Также необходимо отказаться от приема лекарственных средств, увеличить число продуктов, содержащих витамин В12.
Нельзя заниматься самолечением. Это может негативно отразиться на здоровье человека. Необходимое лечение может назначить только лечащий врач.
Со временем показатели крови сильно меняются. Поэтому при возникновении повышенного или пониженного уровня кровяных частиц вдаваться в панику не стоит. Полученный анализ необходимо показатель профессиональному специалисту. Врач должен внимательно изучить данные, дать пациенту рекомендации и назначить соответствующее лечение. Это поможет избежать каких-либо недоразумений. Также стоит учесть, что каждая лаборатория проводит свои исследования. Показатели и отклонения от нормы могут различаться. Расхождение данных может быть причиной разного оборудования, опыта квалифицированных работников. Отклонения от нормы не являются самой болезнью.
Вопрос-ответ
Что означает коэффициент анизоцитоза эритроцитов?
Анизоцитоз эритроцитов в общем анализе крови говорит о том, что размер красных кровяных телец отклонился от стандартного в сторону. В норме их величина составляет от 7,5 до 8,3 мкм. В крови могут присутствовать эритроциты, размер которых отклоняется, но их число не должно превышать 30%.
Что означает повышенный RDW-CV в анализе крови?
RDW (ширина распределения эритроцитов) в анализе крови повышен чаще всего в результате развития анемии. Несколько типов анемий, связанных с повышенным уровнем RDW, включают следующие: железодефицитная анемия; анемия, вызванная дефицитом витамина B12 и фолиевой кислоты.
О чем говорит индекс распределения эритроцитов?
Индекс RDW-CV измеряется в процентах и показывает, насколько сильно размер эритроцитов отклоняется от нормального. Норма RDW-CV — 11–15% от общего количества эритроцитов в пробе. Именно такое количество «неправильных» по размеру эритроцитов допустимо и не считается патологией.
Советы
СОВЕТ №1
Изучите основные понятия, связанные с коэффициентом анизотропии эритроцитов, чтобы лучше понимать его значение и влияние на здоровье. Это поможет вам осознанно подходить к вопросам диагностики и лечения.
СОВЕТ №2
Обратите внимание на результаты анализов, особенно если у вас есть хронические заболевания или вы находитесь в группе риска. Изменения в коэффициенте анизотропии могут указывать на проблемы с кроветворением или другие патологии.
СОВЕТ №3
Консультируйтесь с врачом по поводу интерпретации результатов анализов. Профессиональная оценка коэффициента анизотропии эритроцитов может помочь в выявлении заболеваний на ранних стадиях и выборе правильной стратегии лечения.
СОВЕТ №4
Следите за своим образом жизни: правильное питание, физическая активность и отказ от вредных привычек могут положительно сказаться на состоянии крови и, соответственно, на коэффициенте анизотропии эритроцитов.










